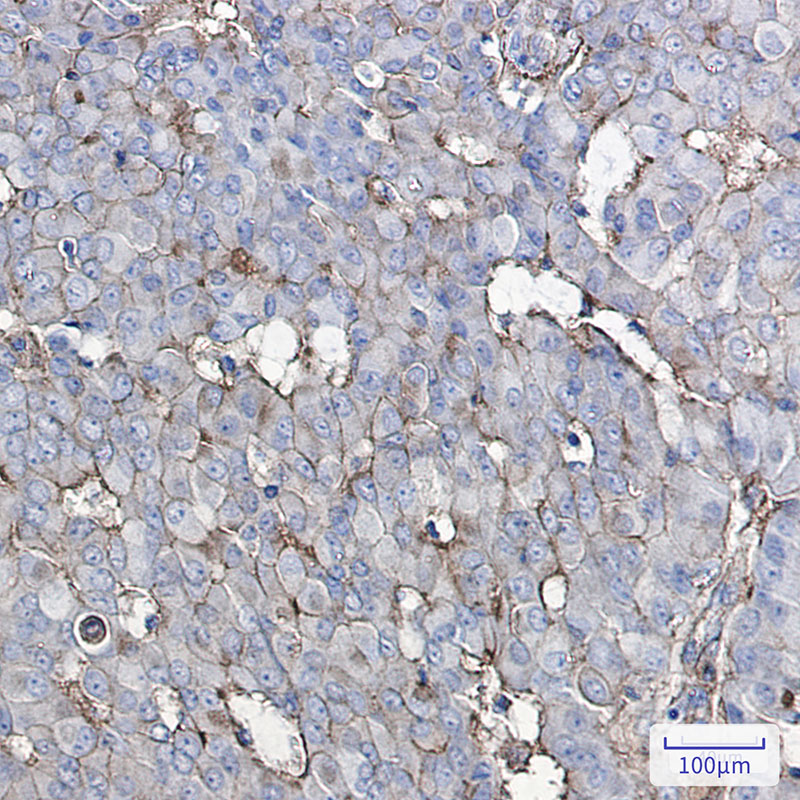
2 - GNAQ Rabbit mAb AP75508

GNAQ Rabbit mAb
- 产品详情
- 实验流程
- 背景知识
Application
| WB, IHC-P, FC, IP |
|---|---|
| Primary Accession | P50148 |
| Reactivity | Rat, Human, Mouse |
| Host | Rabbit |
| Clonality | Monoclonal Antibody |
| Isotype | IgG |
| Conjugate | Unconjugated |
| Purification | Affinity Purified |
| Calculated MW | 42142 Da |
| Gene ID | 2776 |
|---|---|
| Other Names | GNAQ |
| Dilution | WB~~1:500-1:1000 IHC-P~~1:50~200 FC~~1:20-1:50 IP~~1:20-1:50 |
| Format | Liquid in 50mM Tris-Glycine(pH 7.4), 0.15M NaCl, 40%Glycerol, 0.01% sodium azide and 0.05% BSA. |
| Storage | Store at 4°C short term. Aliquot and store at -20°C long term. Avoid freeze/thaw cycles. |
| Name | GNAQ (HGNC:4390) |
|---|---|
| Synonyms | GAQ |
| Function | Guanine nucleotide-binding proteins (G proteins) function as transducers downstream of G protein-coupled receptors (GPCRs) in numerous signaling cascades (PubMed:34556863, PubMed:35672283, PubMed:37991948). The alpha chain contains the guanine nucleotide binding site and alternates between an active, GTP-bound state and an inactive, GDP-bound state (PubMed:37991948). Signaling by an activated GPCR promotes GDP release and GTP binding (PubMed:37991948). The alpha subunit has a low GTPase activity that converts bound GTP to GDP, thereby terminating the signal (PubMed:37991948). Both GDP release and GTP hydrolysis are modulated by numerous regulatory proteins (PubMed:37991948). Signaling is mediated via phospholipase C-beta- dependent inositol lipid hydrolysis for signal propagation: activates phospholipase C-beta: following GPCR activation, GNAQ activates PLC- beta (PLCB1, PLCB2, PLCB3 or PLCB4), leading to production of diacylglycerol (DAG) and inositol 1,4,5-trisphosphate (IP3) (PubMed:37991948). Required for platelet activation (By similarity). Regulates B-cell selection and survival and is required to prevent B- cell-dependent autoimmunity (By similarity). Regulates chemotaxis of BM-derived neutrophils and dendritic cells (in vitro) (By similarity). Transduces FFAR4 signaling in response to long-chain fatty acids (LCFAs) (PubMed:27852822). Together with GNA11, required for heart development (By similarity). |
| Cellular Location | Cell membrane; Lipid-anchor. Golgi apparatus. Nucleus {ECO:0000250|UniProtKB:P21279} Nucleus membrane {ECO:0000250|UniProtKB:P21279}. Note=Colocalizes with the adrenergic receptors ADRA1A and ADRA1B at the nuclear membrane of cardiac myocytes. {ECO:0000250|UniProtKB:P21279} |
| Tissue Location | Predominantly expressed in ovary, prostate, testis and colon. Down-regulated in the peripheral blood lymphocytes (PBLs) of rheumatoid arthritis patients (at protein level) |
Research Areas
For Research Use Only. Not For Use In Diagnostic Procedures.
Application Protocols
Provided below are standard protocols that you may find useful for product applications.
BACKGROUND
This locus encodes a guanine nucleotide-binding protein. The encoded protein, an alpha subunit in the Gq class, couples a seven-transmembrane domain receptor to activation of phospolipase C-beta. Mutations at this locus have been associated with problems in platelet activation and aggregation. A related pseudogene exists on chromosome 2.
终于等到您。ABCEPTA(百远生物)抗体产品。
点击下方“我要评价 ”按钮提交您的反馈信息,您的反馈和评价是我们最宝贵的财富之一,
我们将在1-3个工作日内处理您的反馈信息。
如有疑问,联系:0512-88856768 tech-china@abcepta.com.
¥ 1,500.00
Cat# AP75508























 癌症的基本特征包括细胞增殖、血管生成、迁移、凋亡逃避机制和细胞永生等。找到癌症发生过程中这些通路的关键标记物和对应的抗体用于检测至关重要。
癌症的基本特征包括细胞增殖、血管生成、迁移、凋亡逃避机制和细胞永生等。找到癌症发生过程中这些通路的关键标记物和对应的抗体用于检测至关重要。 为您推荐一个泛素化位点预测神器——泛素化分析工具,可以为您的蛋白的泛素化位点作出预测和评分。
为您推荐一个泛素化位点预测神器——泛素化分析工具,可以为您的蛋白的泛素化位点作出预测和评分。 细胞自噬受体图形绘图工具为你的蛋白的细胞受体结合位点作出预测和评分,识别结合到自噬通路中的蛋白是非常重要的,便于让我们理解自噬在正常生理、病理过程中的作用,如发育、细胞分化、神经退化性疾病、压力条件下、感染和癌症。
细胞自噬受体图形绘图工具为你的蛋白的细胞受体结合位点作出预测和评分,识别结合到自噬通路中的蛋白是非常重要的,便于让我们理解自噬在正常生理、病理过程中的作用,如发育、细胞分化、神经退化性疾病、压力条件下、感染和癌症。